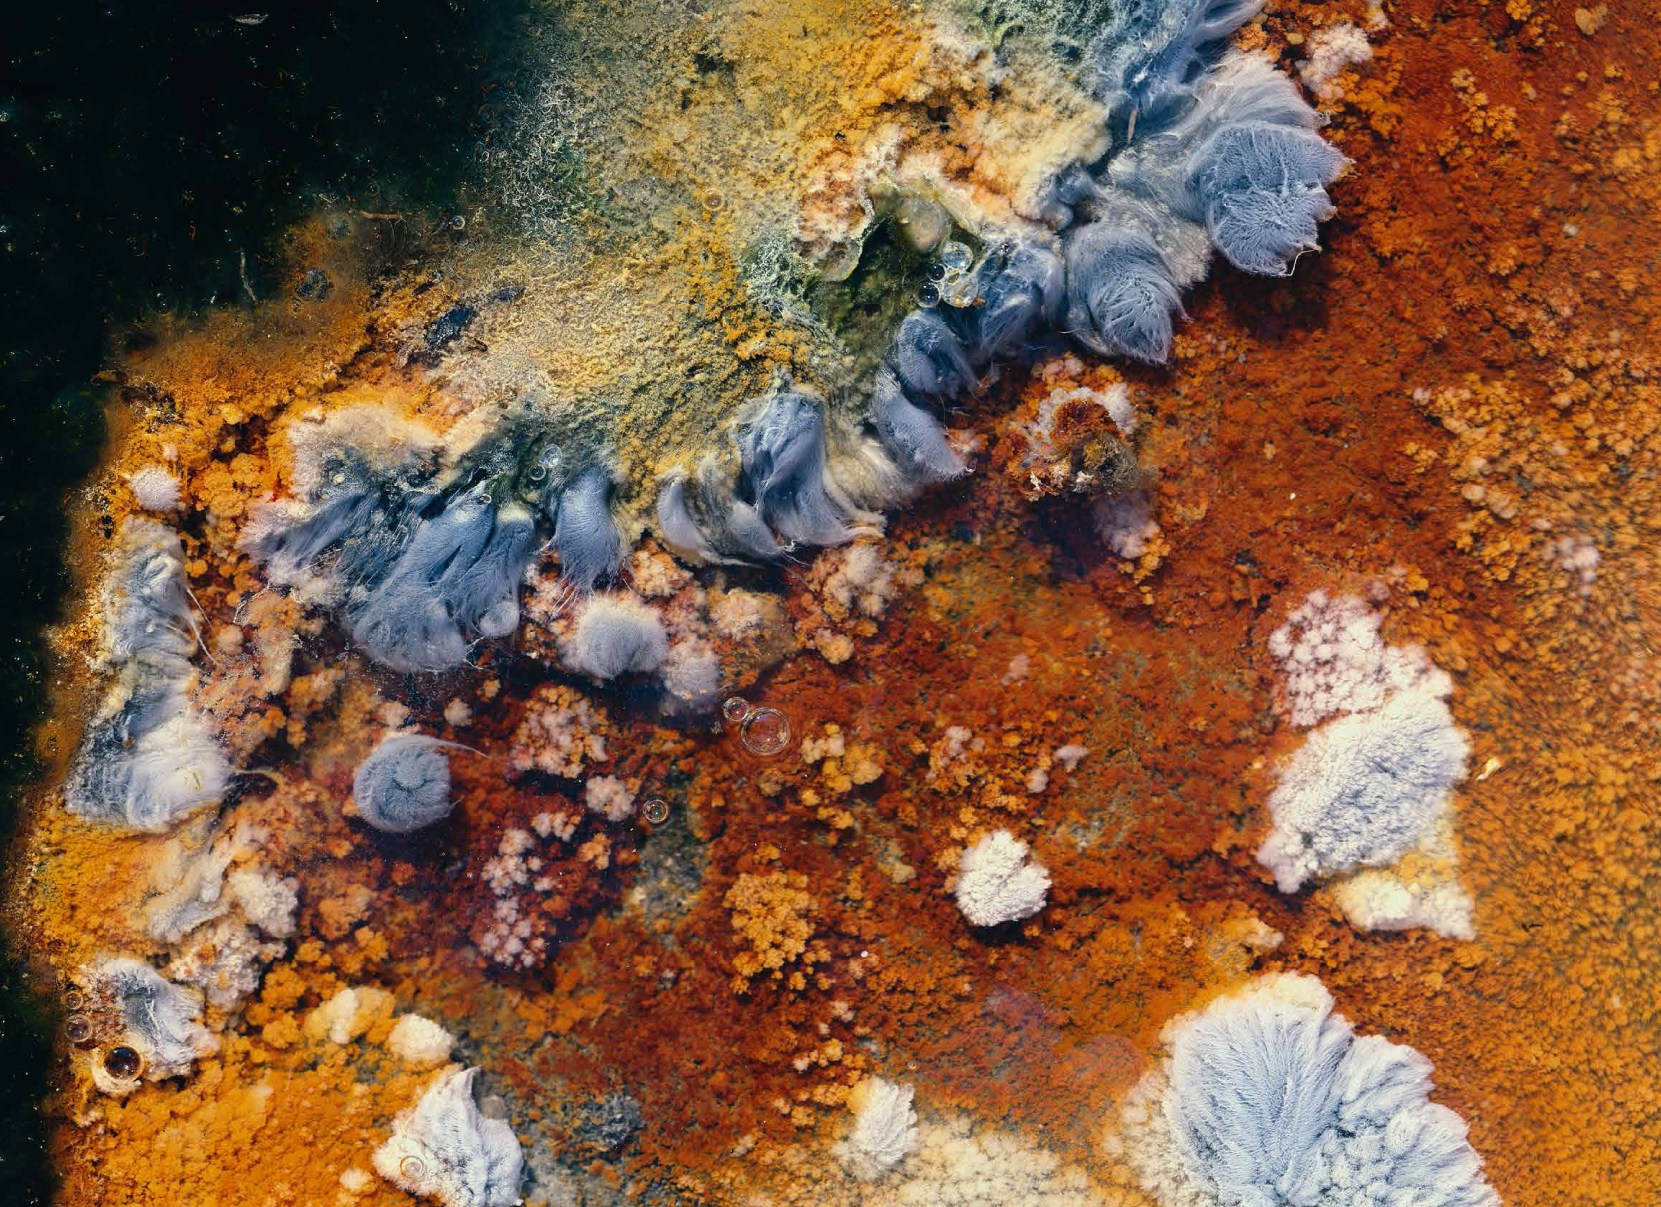
Коллекционные альбомы. ВАДИМ ГИППЕНРЕЙТЕР — ВЕЛИКИЙ ФОТОГРАФ ЗЕМЛИ РУССКОЙ

Коллекционные альбомы
Заказать альбомКоллекционные альбомы
Вышла в свет серия коллекционных подарочных альбомов Вадима Гиппенрейтера.
Кроме представленных на фото есть еще альбомы:
- Мелодии севера,
- Пейзажи средней полосы,
- Тайна зарождения
- Мещера
Альбомы выполнены в едином стиле, большого формата (30×40), напечатаны на качественной фотобумаге. Изготавливаются по индивидуальным заказам. По желанию на титульный лист может быть внесено имя владельца.
Издание имеет особую ценность для собирателей и коллекционеров редких книг и фотографий. Художественный коллекционный альбом — это прекрасный VIP подарок.
По вопросам приобретения просим обращаться:
Мария Гиппенрейтер
Фонд «Фотографическое
наследие Вадима Гиппенрейтера».